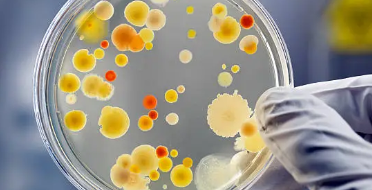

칫솔살균기 직접 쓰고 비교하는 TOP3
칫솔살균기는 최근 들어 위생과 건강을 중시하는 현대인들 사이에서 필수 아이템으로 자리잡고 있습니다. 매일 사용하는 칫솔은 입속 세균과 음식 찌꺼기 등으로 오염되기 쉬워, 적절한 관리가 이루어지지 않으면 다양한 구강 질환을 유발할 수 있습니다. 이러한 문제를 해결하기 위해 칫솔살균기를 사용하는 것이 중요합니다. 이번 글에서는 칫솔살균기를 직접 사용해 보고, 가장 추천할 만한 제품 TOP3를 비교하여 소개하겠습니다. 칫솔살균기의 필요성과 추천 제품, 관리 방법까지 자세히 알아보도록 하겠습니다.

칫솔살균기 써야 하는 이유

칫솔살균기를 사용해야 하는 이유는 크게 세 가지로 요약할 수 있습니다.
첫째, 세균 제거 효과입니다. 칫솔은 입속 세균이 쉽게 번식할 수 있는 환경입니다. 물로 씻어내는 것만으로는 부족하며, 칫솔살균기를 사용하면 자외선(UV-C) 또는 고온 스팀으로 세균을 효과적으로 제거할 수 있습니다. 연구에 따르면, 칫솔살균기는 일반적인 세균의 99.9%를 제거할 수 있다고 합니다.
둘째, 구강 건강 유지입니다. 세균이 번식한 칫솔을 사용하면 구강 내 세균이 증가하여 잇몸 질환, 충치 등 다양한 문제를 일으킬 수 있습니다. 칫솔살균기를 사용하면 칫솔을 항상 깨끗하게 유지할 수 있어 구강 건강을 지키는 데 도움이 됩니다.
셋째, 편리함과 경제성입니다. 칫솔살균기는 한 번 구매하면 오랜 기간 사용할 수 있어 경제적입니다. 또한, 별도의 관리가 필요 없고, 자동으로 작동하는 제품이 많아 사용이 편리합니다. 이러한 이유로 칫솔살균기는 현대인의 생활 필수품으로 자리잡고 있습니다.
칫솔살균기를 사용하지 않을 경우, 칫솔에 붙는 세균 수는 매우 많습니다. 연구에 따르면, 사용 후의 칫솔에는 평균적으로 수백만 개의 세균이 번식할 수 있습니다. 칫솔은 입속 세균뿐만 아니라 욕실 내 공기 중의 세균에도 노출되기 때문입니다. 특히, 욕실은 습기가 많아 세균이 번식하기에 최적의 환경을 제공합니다. 일반적인 칫솔에는 대장균, 연쇄상구균, 포도상구균 등 다양한 세균이 검출될 수 있으며, 이는 구강 질환뿐만 아니라 전신 질환의 원인이 될 수도 있습니다.
칫솔살균기 직접 쓰고 추천하는 추천 제품
이번에는 실제로 사용해 보고 추천할 만한 칫솔살균기 TOP3를 소개합니다.

1) 필립스 소닉케어 칫솔살균기 필립스 소닉케어 칫솔살균기는 강력한 자외선(UV-C) 살균 기능을 제공하여 세균을 효과적으로 제거합니다. 또한, 간편한 사용법과 세련된 디자인으로 많은 사랑을 받고 있습니다. 이 제품은 충전식으로 휴대가 용이하며, 여행 시에도 간편하게 사용할 수 있습니다.

2) 유토렉스 칫솔살균기 유토렉스 칫솔살균기는 자외선 살균과 더불어 열풍 건조 기능을 갖추고 있어 칫솔을 더욱 청결하게 유지할 수 있습니다. 또한, 여러 개의 칫솔을 동시에 살균할 수 있는 다용도 제품으로 가족 단위로 사용하기에 적합합니다. 사용자의 편의를 고려한 자동 타이머 기능도 장점 중 하나입니다.

3) 덴티클린 칫솔살균기 덴티클린 칫솔살균기는 자외선과 고온 스팀을 결합한 듀얼 살균 시스템을 제공하여 최고의 살균 효과를 자랑합니다. 또한, 직관적인 디지털 디스플레이와 터치식 조작이 가능해 사용이 매우 간편합니다. 디자인 또한 모던하고 깔끔해 욕실 인테리어와 잘 어울립니다.



칫솔살균기 관리법
칫솔살균기의 관리법은 다음과 같습니다. 우선, 정기적으로 칫솔살균기의 내부를 청소해 주어야 합니다. 자외선 램프나 고온 스팀 장치에 먼지나 오염물이 쌓이면 살균 효과가 떨어질 수 있습니다. 따라서, 주기적으로 청소하고, 필요 시 교체해 주는 것이 중요합니다.
또한, 칫솔살균기를 사용하지 않을 때는 전원을 차단해 불필요한 에너지 소모를 방지해야 합니다. 장기간 사용하지 않을 경우, 건조하고 서늘한 곳에 보관하는 것이 좋습니다. 마지막으로, 칫솔살균기에 넣는 칫솔은 항상 물기를 제거한 후 넣어야 합니다. 물기가 남아 있으면 곰팡이나 세균이 번식할 수 있기 때문에 주의가 필요합니다.



마치며
칫솔살균기는 구강 건강을 지키기 위한 필수 아이템입니다. 세균 제거 효과, 구강 건강 유지, 편리함과 경제성 등 여러 장점을 가지고 있어 많은 사람들이 사용하고 있습니다. 이번 글에서 소개한 필립스 소닉케어, 브레오, LG전자 퓨리케어 칫솔살균기는 각각의 특장점을 가지고 있어 사용자의 필요에 맞게 선택할 수 있습니다. 또한, 칫솔살균기를 효과적으로 사용하기 위해서는 정기적인 청소와 적절한 보관이 중요합니다. 칫솔살균기를 통해 더욱 건강하고 깨끗한 구강 환경을 유지해 보시기 바랍니다.



'건강' 카테고리의 다른 글
| 파킨슨병 예방에 좋은 음식 (0) | 2024.07.04 |
|---|---|
| 파킨슨병 증상, 치료, 원인 (0) | 2024.07.04 |
| 의사 파업 언제까지 할까? 진료 가능 병원 찾기 (1) | 2024.06.18 |
| 의료 파업 시 진료 가능한 병원 리스트 (0) | 2024.06.17 |
| 여름 보양식 흑염소탕, 흑염소진액 면역력 증진에 최고 (1) | 2024.06.07 |
댓글